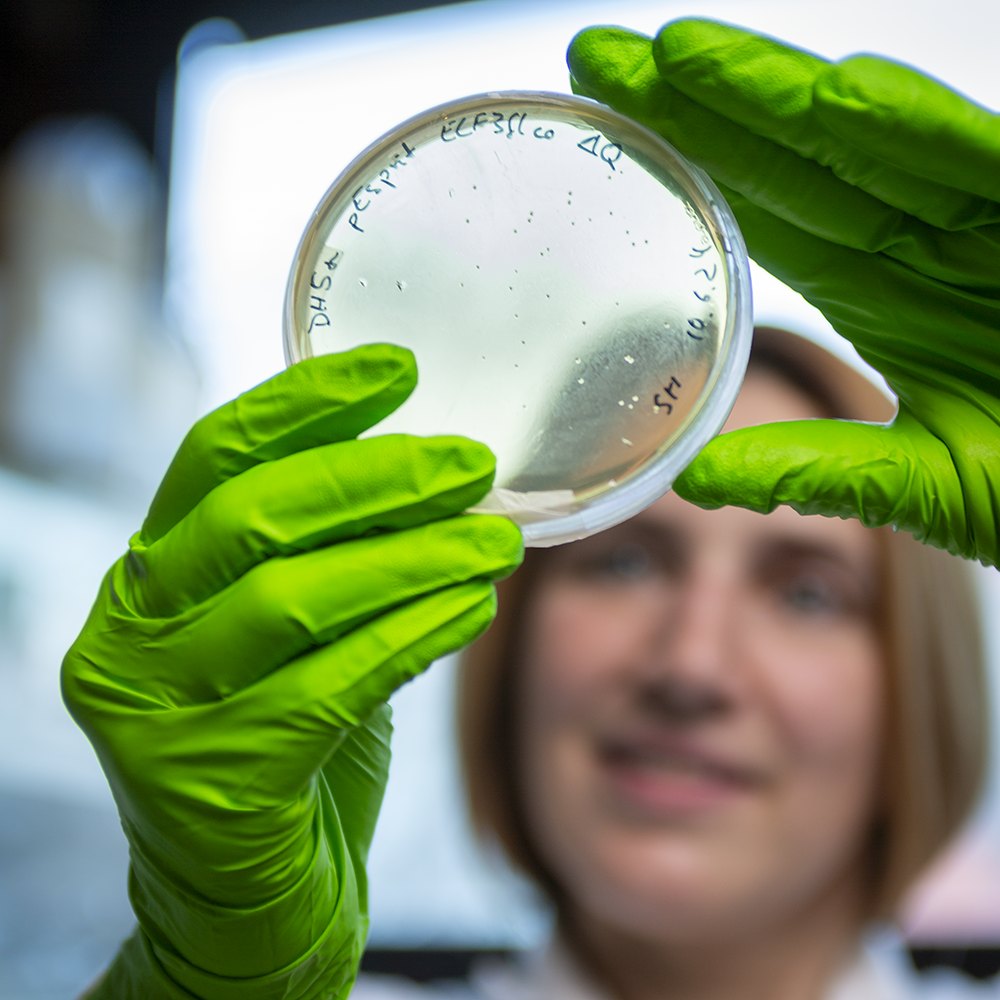

Diaporama "Mécanismes moléculaires de détection de la température chez les plantes"
Dans le règne végétal, un certain nombre de processus tels que la floraison ou encore la germination peuvent être déterminés par la température extérieure. Comment les plantes perçoivent-elles cette température et ses fluctuations ? C’est à cette question que s’est attelé une équipe de scientifiques du Laboratoire de physiologie cellulaire et végétale (LPCV).
Dans le cadre du projet ANR TEMPSENS, l'équipe de recherche s’est intéressée en particulier à la protéine Early flowering 3 (ELF3). Celle-ci joue le rôle de thermocapteur au sein d’un complexe formé de trois protéines et impliqué dans la régulation des processus physiologiques quotidiens des plantes.
Pour les besoins du projet, des bactéries sont modifiées génétiquement, de manière à leur faire produire en grande quantité cette protéine d’intérêt afin, dans un second temps, de l’isoler et de l’analyser. Les bactéries modifiées sont ici observées à l’œil nu pour vérifier leur développement.
La biologie moléculaire est utilisée pour leur donner des instructions génétiques ("cartes") pour la production recombinante des protéines de plantes, comme Early flowering 3 (ELF3).
Cette méthode puissante permet d’explorer le rôle précis de la protéine et d’examiner l’effet de mutations ciblées. Grâce à cette technique, les chercheurs peuvent décrypter les mécanismes moléculaires d’ELF3 impliqués dans la perception de la température par les plantes.

Les protéines végétales sont isolées des bactéries avant d’être purifiées. Puis elles sont séparées par taille et par charge électrique à l’aide d’une technique appelée électrophorèse.
Cette méthode permet de les visualiser et d'analyser leurs caractéristiques, essentielles pour comprendre leur rôle dans les processus biologiques des plantes.

En laboratoire, les scientifiques ont observé que certaines plantes réagissent différemment aux variations de températures et fleurissent plus ou moins tôt, selon la version d'ELF3 qu'elles possèdent. Grâce à l’observation de leur phénotype (morphologie, développement…), ils peuvent observer l’influence de différentes versions de la protéine ELF3 sur la croissance des plantes.
Les plantes peuvent être cultivées dans des pots en terre ou dans des boîtes de Petri.

Les plantules qui poussent dans ces boîtes sont soumises à différents régimes de température et leur taille est mesurée pour comprendre comment elles réagissent aux variations de température. Ici la comparaison est faite entre des végétaux possédant la version sauvage et ceux possédant une version mutée de ELF3.
En cultivant ces plantules dans des conditions contrôlées, les scientifiques peuvent recueillir des données précises et quantitatives, facilitant ainsi l’analyse statistique des effets de la température sur leur croissance.
Afin d’étudier les mécanismes moléculaires à l’œuvre, les tissus des plantes sélectionnés sont traités de manière à n’obtenir que les protoplastes, c’est-à-dire des cellules végétales ne possédant pas de paroi cellulaire.

Ces protoplastes présentent l’avantage d’être facilement transformables avec un transgène qui exprime une protéine d’intérêt marquée par fluorescence, ici ELF 3.
Lors de leur préparation, ils sont filtrés pour ne garder que la matière qui intéresse les scientifiques.

La fluorescence permet aux scientifiques d’étudier la localisation, les interactions et la dynamique moléculaire de ELF3. Cette approche est utilisée pour la visualiser dans ses phases dispersée et condensée, offrant ainsi des informations essentielles sur son comportement face aux variations de température.

Les échantillons de tissus végétaux utilisés pour l’extraction de différentes molécules, comme l’ARN, sont ensuite congelés. Cette méthode permet de préserver les échantillons dans leur état initial, facilitant ainsi l’analyse précise des molécules et de leur rôle dans les processus biologiques des plantes.

La modélisation en trois dimensions de la protéine ELF3 permet d’anticiper ses transformations structurelles en réponse aux variations de température. Ces simulations fournissent des indices sur la forme de la protéine, ses interactions et sa fonction dans la cellule, qui sont ensuite vérifiés en laboratoire. Cette approche efficace offre une meilleure compréhension des mécanismes moléculaires complexes impliqués dans le développement et l’adaptation des plantes face au réchauffement climatique.
Les travaux menés sur EFL3 dans le cadre de TEMPSENS ont permis d’affiner nos connaissances sur le développement des végétaux. Étudier la réponse thermique des plantes grâce à la biologie structurale et à des mutations ciblées permettrait de mieux les préparer aux défis du changement climatique.
_ _ _
Découvrez le reportage photos complet "Mécanismes moléculaires de détection de la température chez les plantes" sur la médiathèque du CNRS.
En savoir plus sur les projets "Science avec et pour la société" (articles, vidéos, conférences…) à destination du plus grand nombre.
_ _ _
Ces recherches ont été financées en tout ou partie, par l’Agence nationale de la recherche (ANR) au titre du projet ANR- TEMPSENS - AAPG2019. Cette communication est réalisée et financée dans le cadre de l’appel à projet Sciences Avec et Pour la Société - Culture Scientifique Technique et Industrielle pour les projets JCJC et PRC des appels à projets génériques 2018-19 (SAPS-CSTI-JCJC et PRC AAPG 18-19).
----------------------------------------------------------------------------
Crédit photos : © Christian MOREL / LPCV / CNRS Images
Texte : Stephanie Hutin / LPCV ; Chloe Zubieta / LPCV ; CNRS Alpes